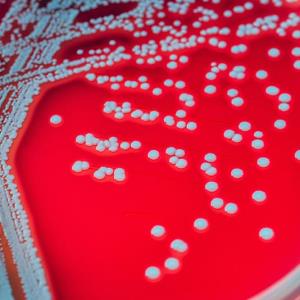

The European Society of Clinical Microbiology and Infectious Diseases 34th Congress (ESCMID Global 2024)
Barcelona, Spain 27 April 2024 - 30 April 2024
Prophylactic intranasal IFN-α cuts COVID-19 incidence in cancer patients
20 May 2024
byAudrey Abella
Prophylactic interferon-alpha (IFN-α) administered intranasally slashed the incidence of COVID-19 by almost half in a cohort of cancer patients in the C-SMART study.
Prophylactic intranasal IFN-α cuts COVID-19 incidence in cancer patients
20 May 2024
RSV vaccine plus flu or COVID-19 shots safe, feasible in older adults
13 May 2024
byStephen Padilla
Coadministration of mRNA-1345, a respiratory syncytial virus (RSV) vaccine, with an influenza (flu) or a COVID-19 vaccine in older adults exhibits good tolerability and has an acceptable reactogenicity profile, according to a US study presented at ESCMID Global Congress 2024.